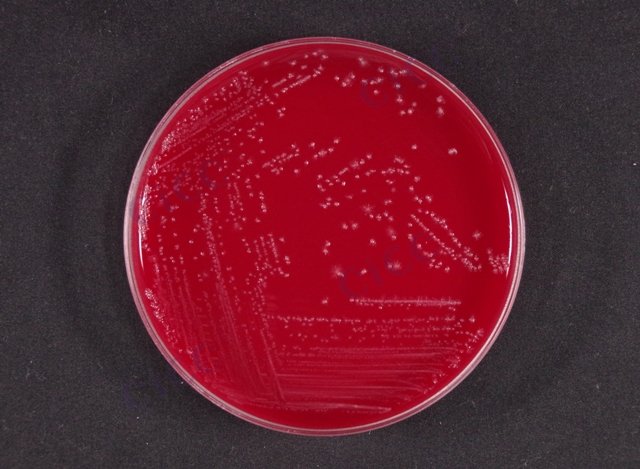
生孢梭菌 Clostridium sporogenes CICC 10385 Clostridium sporogenes

生孢梭菌 Clostridium sporogenes CICC 10385 Clostridium sporogenes
-
生孢梭菌 Clostridium sporogenes CICC 10409 Clostridium sporogenes
CICC 10409 | 见证书
-
生孢梭菌 Clostridium sporogenes CICC 25026 Clostridium sporogenes
CICC 25026 | 见证书
-
生孢梭菌 Clostridium sporogenes CICC 8021 Clostridium sporogenes
CICC 8021 | 见证书
-
生孢梭菌 Clostridium sporogenes
BNCC368421 | 冻干粉;平板
-
生孢梭菌 Clostridium sporogenes
BNCC336899 | 冻干粉;菌液;平板
-
生孢梭菌 Clostridium sporogenes
BNCC372681 | 冻干粉;菌液;平板
-
生孢梭菌 Clostridium sporogenes
BNCC185999 | 冻干粉;菌液;平板

说明书下载: 菌种说明书 打管说明书
您正在浏览的产品:生孢梭菌 Clostridium sporogenes CICC 10385
手机版:生孢梭菌 Clostridium sporogenes CICC 10385
本公司销售的所有产品仅供实验科研使用,不用于人体及临床诊断。
适用于药品、食品及微生物检测中生孢梭菌的定性/定量分析,特别针对培养基灵敏度验证、无菌检查及微生物限度检测[3][6]。
1. 厌氧培养法:使用硫乙醇酸盐流体培养基(FTM)或庖肉培养基,36℃培养24-48小时;
2. 菌落形态观察:血平板或哥伦比亚琼脂平板上呈淡黄色不规则菌落;
3. 生化鉴定:触酶试验阴性,代谢特征验证[8][9]。
1. 液体培养基灵敏度:≤10 CFU/mL;
2. 固体培养基检出限:单个菌落可识别;
3. 定量检测范围:101-107 CFU/g(依据样品基质调整)[3][6]。
1. 标准菌株来源:ATCC 19404、CMCC(F)98001等权威保藏机构;
2. 传代控制:工作菌株传代不超过5代;
3. 保存条件:冻干粉-80℃保存,液体菌种需6个月内使用[3][6][9]。
1. 活化:厌氧环境下接种至FTM或血平板;
2. 纯化:挑取单菌落进行革兰染色确认(G+杆菌,芽孢卵圆形);
3. 验证:通过代谢产物分析(丁酸、乙酸检测)[8][9]。
1. 严格厌氧操作:需在厌氧工作站或培养袋内操作;
2. 生物安全:实验废弃物需121℃高压灭菌30分钟;
3. 时效性:活化后48小时内使用,避免菌体自溶[8][9]。
以上信息仅供参考,请以相应标准的原文为准!